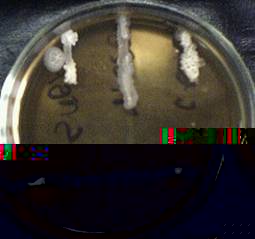

Влияние антибиотиков на развитие микроорганизмов
Выдающееся открытие А. Флемингом пенициллина привело к тому, что возникла наука об антибиотиках, была создана мощная промышленность по их производству, не имеющая предшественников. В результате антибиотики приобрели социальное значение, повлияли на экономику. Но только 2-3 % открытых антибиотиков было использовано в клинике, а также сельском хозяйстве и некоторых отраслях пищевой промышленности.
Отмечая широкие возможности использования антибиотиков в лечебных целях, разрабатывая методы, позволяющие преодолевать множественную лекарственную устойчивость у микроорганизмов, нельзя не учитывать очень важного фактора, который приобретает всё большую актуальность: это влияние антибиотиков на окружающую среду. В результате деятельности человека количество антибиотиков во внешней среде возрастает.
Среди важных вопросов, связанных с проблемой Влантибиотики и внешняя средаВ», немалое значение приобрело влияние антибиотиков на различные почвенные биоценозы. Микрофлора в различных населённых пунктах, на территории лечебных учреждений, на предприятиях, производящих препараты, на животноводческих фермах, микрофлора сточных вод благодаря применению антибиотиков изменилась. Без микробов существование почвы невозможно, так как они являются необходимым звеном в круговороте всех биогенных элементов, участвуют в почвообразовании и поддержании почвенного плодородия. Таким образом антропогенное воздействие, нарушающее почвенные биоценозы, заключается в попадании и накапливании в почве химических соединений, к которым относятся и антибиотики.
Кроме того, на микрофлору почвы влияют не только антибиотики, занесённые в результате деятельности человека, но и антибактериальные вещества тАУ продукты жизнедеятельности микроорганизмов-антагонистов (некоторые бактерии и грибы). Подавляя и уничтожая представителей микрофлоры почвы, антагонисты имеют большое значение в почвообразовательных процессах.
Таким образом, с целью упорядоченности применения антибиотиков и изучается их воздействие на микроорганизмы.
Целью данной работы является изучение влияния различных антибиотиков на типичных представителей микрофлоры почвы тАУ бактерий рода Bacillus.
Род Bacillus объединяет подвижные палочковидные клетки, размеры которых колеблются в довольно широких пределах. Жгутики расположены перитрихиально. Окрашивание по Граму различно: положительно или положительно только в молодой культуре. Облигатные или факультативные аэробы. Бактерии рода Bacillus синтезируют различные литические ферменты, расщепляющие полисахариды, белки, жиры и другие макромолекулы. Некоторые виды образуют антибиотики, такие как бацитрацин, субтилизин. Большинство бацилл тАФ сапрофиты. Основное место их обитания тАФ почва. Есть среди них и патогенные для животных и человека формы, например B. anthracis тАФ возбудитель сибирской язвы, а также виды, вызывающие различные заболевания членистоногих. (М.В. Гусев, Л.А. Минеева,1992)
Задачи курсовой работы:
1. Определить чувствительность бактерий рода Bacillus к различным антибиотикам (пенициллин, ампициллин, стрептомицин), то есть задержку роста культуры в присутствии антибиотика, диффундирующего в среду.
2. Изучить интенсивность роста колоний данного микроорганизма при различных концентрациях антибиотика, растворённого в питательной среде.
Глава 1. Литературный обзор
1.1 История открытия антибиотиков
Учение об антибиотиках - молодая синтетическая ветвь современного естествознания. Впервые в 1940 году был получен в кристаллическом виде химиотерапевтический препарат микробного происхождения тАУ пенициллин - антибиотик, открывший летоисчисление эры антибиотиков.
Многие учёные мечтали о создании таких препаратов, которые можно было бы использовать при лечении различных заболеваний человека, о препаратах, способных убивать патогенных бактерий, не оказывая вредного действия на организм больного.
Пауль Эрлих (1854-1915) в результате многочисленных опытов синтезировал в 1912 году мышьяковистый препарат - сальварсан, убивающий in vitro возбудителя сифилиса. В 30-х годах прошлого столетия в результате химического синтеза были получены новые органические соединения тАУ сульфамиды, среди которых красный стрептоцид (пронтозил) был первым эффективным препаратом, оказавшим терапевтическое действие при тяжёлых стрептококковых инфекциях.
В 1937 году в нашей стране был синтезирован сульфидин тАУ соединение, близкое к пронтозилу. Открытие сульфамидных препаратов и применение их в медицинской практике составило известную эпоху в химиотерапии многих инфекционных заболеваний, в том числе сепсиса, менингита, пневмонии, рожистого воспаления, гонореи и некоторых других.
Луи Пастер и С. Джеберт в 1877 году сообщили, что аэробные бактерии подавляют рост Bacillus anthracis.
В конце XIX века В. А. Манассеин (1841-1901) и А. Г. Полотебнов (1838-1908) показали, что грибы из рода Penicillium способны задерживать в условиях in vivo развитие возбудителей ряда кожных заболеваний человека.
И. И. Мечников (1845 - 1916) ещё в 1894 году обратил внимание на возможность использования некоторых сапрофитных бактерий в борьбе с патогенными микроорганизмами.
В 1896 году Р. Гозио из культурной жидкости Penicillium brevicompactum выделил кристаллическое соединение - микофеноловую кислоту, подавляющее рост бактерий сибирской язвы.
Эммирих и Лоу в 1899 году сообщили об антибиотическом веществе, образуемом Pseudomonas pyocyanea, они назвали его пиоцианазой; препарат использовался в качестве лечебного фактора как местный антисептик.
В 1910-1913 годах O. Black и U. Alsberg выделили из гриба рода Penicillium пеницилловую кислоту, обладающую антимикробными свойствами.
В 1929 году А. Флемингом был открыт новый препарат пенициллин, который только в 1940 году удалось выделить в кристаллическом виде.
С получением пенициллина как препарата (1940 год) возникло новое направление в науке тАУ учение об антибиотиках, которое необычайно быстро развивается в последние десятилетия.
В 70-х годах ежегодно описывалось более 300 новых антибиотиков. В 1937 году Вельш описал первый антибиотик стрептомицетного происхождения актимицетин, в 1939 году Красильниковым и Кореняко был получен мицетин и Дюбо тАУ тиротрицин. Впоследующем число антибиотиков росло очень быстрыми темпами.
1.2 Классификация антибиотиков
В зависимости от природы антибиотика, его концентрации, времени действия, микроструктуры клетки организма и внешних условий тАУ температуры рН и других, антибиотические вещества могут проявлять цитостатическое (задерживать рост микробов), цитоцидное (убивать клетки) или цитолитическое (растворять клеточную оболочку и в результате этого приводить к гибели клетки) действие.
По спектру действия антибактериальные антибиотики делятся на: узкого (действующие на грамположительные или грамотрицательные бактерии) и широкого (действующие на грамположительные и грамотрицательные бактерии) спектра действия, противотуберкулёзные, противогрибковые, противоопухолевые, противоамёбные антибиотики.
Классификация антибиотиков по механизму биологического действия:
1. Антибиотики, ингибирующие синтез клеточной стенки (пенициллины, бацитрацин и др.).
2. Антибиотики, нарушающие функции мембран (альбомицин, грами-цидин и др.).
3.Антибиотики, избирательно подавляющие синтез РНК (новобиоцин, актиномицин и др.); ДНК (новобиоцин, актидион и др.).
4. Антибиотики, подавляющие синтез белка (тетрациклины, эритро-мицин, хлорамфеникол и др.).
5. Антибиотики тАУ ингибиторы дыхания (антимицины и др.).
6. Антибиотики тАУ ингибиторы окислительного фосфорилирования (вали-номицин, грамицидины и др.).
7. Антибиотики, обладающие антиметаболитными свойствами.
1.3 Влияние антибиотиков на бактерии рода Bacillus
В Таблице 1 представлено воздействие различных антибиотиков на грамположительные бактерии, к которым и относятся изучаемые в данной курсовой работе бактерии рода Bacillus.
Цифрами в Таблице 1 показана степень эффективности антибиотика: 0 тАУ вообще неэффективны; 1 тАУ эффективны в отношении лишь отдельных представителей; 2 тАУ эффективны в отношении нескольких представителей; 3 тАУ эффективны в отношении большинства форм.
Таблица 1
Воздействие антибиотиков на грамположительные бактерии (Егоров Н.С.,1986)
| Тетрациклин | Хлортетрациклин | Эритромицин | Карбомицин | Фумагиллин | Нистамин | Тиротрицин | Полимиксины | Бацитрацины | Неомицин | Пенициллин | Хлорамфеникол | Стрептомицин |
| 3 | 3 | 3 | 3 | 0 | 0 | 3 | 0 | 3 | 2 | 3 | 2 | 2 |
Вообще, на грамположительные бактерии и в частности на бактерии рода Bacillus воздействуют антибиотики различного спектра биологического действия. Так, антибиотики узкого спектра действия активны преимущественно в отношении грамположительных организмов. На развитие бактерий рода Bacillus влияют такие группы антибиотиков как биосинтетические пенициллины (бензилпенициллин и его соли), полусинтетические пенициллины (пропициллин, оксациллин), макролиды (эритромицин, лейкомицин), а также альбомицин, новобиоцин, линкомицин и другие.
Антибиотики группы пенициллина ингибируют синтез клеточной стенки бактерий, новобиоцин подавляет синтез РНК и ДНК, эритромицин тАУ ингибитор синтеза белка в бактериальной клетке.
Следует отметить также то, что некоторые штаммы бактерий рода Bacillus могут образовывать фермент пенициллиназу (иногда и фермент амидазу), разрушающий пенициллин. Появление устойчивости к пенициллину и его производным наблюдается у различных штаммов Bacillus cereus и Bacillus subtilis, что связано с образованием пенициллиназы.
Довольно сильной антибиотической активностью по отношению к грамположительным бактериям обладают антибиотики широкого спектра действия. На рост и развитие бактерий рода Bacillus активно влияют такие антибиотики, как тетрациклины, хлорамфеникол и неомицин (подавляют синтез белка в бактериальной клетке), грамицидин С (ингибитор окислительного фосфорилирования), а также ампициллин, стрептомицин.
В данной курсовой работе будет изучаться влияние на бактерии рода Bacillus антибиотиков группы пенициллина (бензилпенициллин и ампициллин) и стрептомицина.
Широкий интерес к пенициллину как антибиотику появился только в 1940 году, когда препарат был получен Флори и Чейном в химически чистом виде. После того как было установлено, что пенициллин обладает мощными лечебными свойствами, начались интенсивные поиски продуцентов этого антибиотика. Пенициллин могут образовывать многие виды Penicillium(Penicilliumchrysogenum, P. brcvicompactum, P. nigricans, P. turbatum, P. steckii, P. corylophilum), а также некоторые виды Aspergillus(Aspergillusflavus, Asp. flavipes, Asp. janus, Asp. nidulansи др.). Есть указания, что пенициллин образуется также термофильным организмом Malbranchiapulchella.
Первые выделенные из естественных субстратов штаммы Penicilliumкак наиболее активные продуценты пенициллина образовывали не более 20 единиц (12 мкг) антибиотика на 1 мл культуральной жидкости. Даже промышленное производство этого ценнейшего препарата было начато при активности культуральной жидкости не выше 30 мкг!мл или 50 ед/мл. Насколько низка эта активность, можно судить по тому факту, что в настоящее время в промышленных условиях получают культуральные жидкости с содержанием пенициллина до 5000 ед!мл, а отдельные штаммы способны синтезировать антибиотик в количестве 10тАФ15 тыс. ед/мл (Егоров Н. С.,1986).
Большое значение в настоящее время имеет так называемый полусинтетический (биологический + химический) способ получения аналогов природного пенициллина, обладающих рядом ценных свойств. Этим способом и получен кислотоустойчивый и широкоспектровый препарат тАУ ампициллин (a- d- аминобензилпенициллин), который как и все известные пенициллины подавляет синтез клеточной стенки бактерий.
Процесс биосинтеза пенициллина необходимо проводить при самом тщательном соблюдении стерильности всех операций тАФ загрязнение культур посторонней микрофлорой вызывает резкое снижение накопления антибиотика. Известно, что многие бактерии, обычно встречающиеся в воздухе (Вас. subtilis, Вас. mesentericus, Вас. megatherium, Вас. cereus, Bact. collи др.), способны образовывать фермент пенициллиназу, расщепляющий пенициллин. Особенно активными продуцентами пенициллиназы являются Вас. subtilisи Вас. cereus. Загрязнение культуры гриба одной из этих бактерий может привести к резкому падению количества антибиотика в культуральной жидкости.
Вопросу рассмотрения антибиотической активности пенициллина в отношении ряда микроорганизмов уделено достаточно много внимания. Установлено, что пенициллин оказывает антимикробное действие в отношении некоторых грамположительных бактерий (стафилококков, стрептококков, диплококков и некоторых др.) и практически неактивен в отношении грамотрицательпых видов и дрожжей.
По характеру действия па микроорганизмы пенициллин является бактериостатическим и при определенных концентрациях бактериоцидным антибиотиком. Различные типы пенициллинов обладают различной степенью биологической активности.
Чувствительные к пенициллину микроорганизмы относительно легко и быстро приобретают устойчивость к антибиотику. Микроорганизмы, приобретшие устойчивость к одному из типов пенициллина, как правило, резистентны и к другим типам пенициллина. У некоторых бактерии устойчивость к пенициллинам сопровождается способностью образовывать пенициллиназу.
Ваксман и его сотрудники в 1944 г. открыли замечательный антибиотический препарат стрептомицин, выделенный из культуры Act. griseus. Актиномицет, образующий стрептомицин, был впервые выделен в лаборатории микробиологии Ратжерского университета в 1943 г.
Первое сообщение о выделении антибиотика было сделано Шатц, Буги и Ваксманом в январе 1944 г. Антибиотик получил название стрептомицин (от родового названия актиномицетов Streptomyces).
Красильниковым культура актиномицета, образующая стрептомицин, отнесена к Act. globisporusи названа Act. globisporusstreptomyciniпозднее он предложил назвать организм, образующий стрептомицин, Act. streptomycini.
Стрептомицин образуют не только штаммы Act. streptomycini, по и другие актиномицеты тАФ Act. bikiniensis, Act. raneus, Act. humidus, Act. reticuli, Act. griseocarneus, Act. mashuensis. Однако основным продуцентом стрептомицина является Act. streptomycin.
Поотношению к стрептомицину все микроорганизмы условно можно разделить на три группы (Шемякин, Хохлов и др., 1961).
1. Весьма чувствительные микроорганизмы, которые подавляются в большинстве случаев 10 мкг/мл. Сюда можно отнести организмы, принадлежащие к следующим родам: Bacillus, Bordetella, Brucella, Klebsiella, Mycobacterium, Bacteriumи некоторые другие.
2. Умеренно чувствительные, для подавления которых in vitro необходимо иметь концентрацию стрептомицина в пределах 10тАФ100 мкг/мл. К этой группе могут быть отнесены многие бактерии из родов Aerobacter, Corynebacterium, Diplococcus, Proteus, Staphylococcus, Streptococcus, Vibrio.
3. Устойчивые формы микробов, для подавления которых необходима концентрация антибиотика, превышающая 100 мкг/мл. Сюда относятся роды Bacteroides, Clostridium, некоторые виды Proteus, многие виды грибов, дрожжей, риккетсии, вирусы.
Итак, различные организмы по-разному реагируют на присутствие в среде стрептомицина. Наряду с тем, что стрептомицин подавляет рост многих видов микроорганизмов, к нему довольно легко появляется устойчивость, возникают резистентные к стрептомицину формы бактерий.
По антибактериальному спектру стрептомицин существенно отличается от пенициллина тАФ его биологическое действие проявляется не только в отношении грамположительных бактерий, но и в отношении грамотрицательных и кислотоустойчивых микробов. В отличие от пенициллина стрептомицин проявляет антибиотическое действие на бактерии не только в фазе их логарифмического роста, но и в фазе покоя. Различие в биологическом действии пенициллина и стрептомицина состоит также и в том, что, как правило, устойчивые к пенициллину микробы оказываются чувствительными к стрептомицину.
В отличие от пенициллина, стрептомицин поглощается клетками микробов в зависимости от его концентрации в среде: чем выше концентрация антибиотика в среде, тем больше его поглощается клеткой.
Установлено, что стрептомицин оказывает глубокое и разнообразное влияние на обмен веществ чувствительных к нему микроорганизмов. Антимикробное действие этого препарата в основном состоит в том, что он тормозит синтез белка в клетке бактерий.
Этому процессу уделяется большое внимание при изучении механизма действия стрептомицина.
Бактерии рода Bacillus весьма чувствительны к стрептомицину (Таблица 2), который подавляет рост данных микроорганизмов даже при концентрации 10 мкг/мл.
Таблица 2
Антибиотическая активность стрептомицина invitro по отношению к бактериям рода Bacillus (Егоров Н.С.,1986)
| Микроорганизмы | Концентрация стрептомицина (мкг/мл), вызывающая подавление | ||
| наиболее чувствительных штаммов | наиболее устойчивых штаммов | большинство штаммов | |
| Bacillus anthracis | 0.250 | 10 | 5 |
| Bacillus cereus | 0.830 | 2 | 1 |
| Bacillus megatherium | 0.250 | 4 | 2 |
| Bacillus subtilis | 0.056 | 128 | 25 |
Так как бактерии рода Bacillus являются представителями грамположительных бактерий, то на их развитие и рост оказывают влияние большинство антибиотиков, влияющих на эту группу микроорганизмов.
Глава 2. Объекты и методы исследований
2.1 Объекты исследований
В качестве объектов исследований взяли штаммы бактерий рода Bacillus из коллекции кафедры ВлПрикладная биология и микробиологияВ». В частности, в данной курсовой работе изучаем влияние различных антибиотиков на таких представителей рода Bacillus, как Bacillus cereus, Bacillus subtilis и Bacillus mesentericus. Для исследований взяли только чистые культуры микроорганизмов, выращенные на МПА.
В ходе исследований применяли следующие антибиотики: бензилпенициллина натриевая соль (1000000 единиц), стрептомицина сульфат (1 г), ампициллин (0,5 г).
2.2 Методы исследований
Для определения чувствительности микроорганизмов к антибиотикам использовали методы диффузии в агар с использованием желобка, метод титров (серийных разведений) в плотных средах. (И. С. Дзержинская,2005)
2.2.1 Метод диффузии в агар с использованием желобка (опыт А. Флеминга)
Оборудование: 3 чашки Петри с ПА, стерильные пинцеты и скальпели, раствор антибиотика, суспензии культур исследуемых бактерий, бактериологическая петля, спиртовка, линейка.
Ход работы:
1.Приготовили растворы антибиотиков.
1.1. 1000000 единиц соли бензилпенициллина (порошок) растворили в 10 мл стерильной дистиллированной воды. Получили концентрацию антибиотика 100000 ед. на 1 мл воды.
1.2. 0.5 г ампициллина растворили в 3 мл стерильной дистиллированной воды. Концентрация антибиотика тАУ 0.66 г на 1 мл воды.
1.3. 1 г стрептомицина растворили в 6 мл стерильной дистиллированной воды. Концентрация антибиотика тАУ 0.66 г на 1 мл воды.
2. Приготовили суспензии культур микроорганизмов: по одной петле культур B.cereus, B. subtilis и B. mesentericus внесли в пробирки с 9 мл стерильной воды.
3. В чашках Петри с застывшим питательным агаром стерильным скальпелем сделали по одному желобку вдоль всей чашки (ширина желобка 0.5 см, глубина агарового слоя 1 см). Желобки заполнили растворами антибиотиков (в каждом желобке по 0.6 мл соответствующего антибиотика).
4.В каждую чашку Петри с антибиотиком посеяли по три культуры бактерий в виде полосок, перпендикулярных к желобку. Выращивали при комнатной температуре двое суток.
5.Измерили диаметр зоны отсутствия роста микроорганизмов.
2.2.2 Метод титров (серийных разведений) в плотных средах
Цель: изучить влияние различных концентраций пенициллина и стрептомицина на рост представителя рода Bacillus тАУ В. cereus.
Оборудование: стрептомицин и соль бензилпенициллина, суспензия культуры В. cereus, пробирки с 10 мл воды для разведений, стерильные пипетки на 1 мл, пробирки с 4 мл питательного агара, бактериологическая петля, спиртовка.
Ход работы:
1. Приготовление серийных разведений антибиотиков.
1.1. Растворили по 1000000 единиц стрептомицина и соли бензилпенициллина (1 г и 0.5 г порошка соответственно) в пробирках с 10 мл воды. Концентрация антибиотиков тАУ 100000 ед./мл.
1.2. Из предыдущего разведения взяли стерильной пипеткой по 1 мл раствора каждого антибиотика и внесли в пробирки с 10 мл стерильной воды.
Концентрация антибиотиков тАУ 10000 ед./мл.
1.3.По приведённой схеме (пункт 1.2.) приготовили разведения антибиотиков с концентрациями тАУ 1000 ед./мл, 100ед./мл и 10 ед./мл.
2. Внесли стерильной пипеткой по 1 мл каждого разведения (10000 ед./мл, 1000 ед./мл, 100 ед./мл, 10ед./мл) в пробирки, содержащие по 4 мл расплавленной и охлаждённой агаризованной среды, скосили пробирки до застывания агара.
3. На поверхность плотной среды петлёй засеяли взвесь культуры B. cereus. Посевы выращивали 18-20 часов.
4. Отметили различную интенсивность роста микроорганизмов при разных концентрациях антибиотика.
Глава 3. Результаты исследований
В ходе курсовой работы изучили влияние таких антибиотиков, как стрептомицин, пенициллин, ампициллин, на грамположительные бактерии рода Bacillus: Bacillus subtilis, Bacillus mesentericus, Bacillus cereus.
Bacillus cereus образовал выпуклые колонии белого цвета с расползающимися краями, блестящие, слизистые; Bacillus subtilis тАУ мутно-белые, слизистые, выпуклые колонии с расползающимися краями; Bacillus mesentericus тАУ прозрачно-серые, плоские, блестящие, слизистые колонии с расползающимися краями.
В результате исследований методом диффузии в агар с использованием желобка получили следующие результаты:
1. В чашке Петри с бензилпенициллином наблюдали задержку роста колоний микроорганизмов, т. е. расстояние от края желобка до начала роста колоний. Задержка роста культуры, Bacillus subtilis составила 2 см, Bacillus mesentericus тАУ 1.5 см, Bacillus cereus - 1 см. Результаты приведены на Рисунке 1 (Приложение 1).
2. Задержка роста при действии ампициллина составила: у Bacillus subtilis тАУ 3.8 см, Bacillus mesentericus тАУ 2.5 см, Bacillus cereus тАУ 3.3 см. Результаты приведены на Рисунке 2 (Приложение 2).
3. В чашке Петри со стрептомицином задержка роста у Bacillus subtilis тАУ 2.2 см, Bacillus mesentericus тАУ 2 см, Bacillus cereus тАУ 2.5 см.
При изучении влияния различных концентраций бензилпенициллина и стрептомицина на культуру Bacillus cereus (метод титров в плотных средах) получили следующие результаты:
1.В пробирках с различной концентрацией стрептомицина в питательной среде наблюдали неодинаковую интенсивность роста колоний. Отсутствием роста микроорганизмов характеризуется пробирка с добавлением антибиотика концентрацией 10000 ед./мл. Наибольшее развитие колоний наблюдали при концентрациях стрептомицина 10 ед./мл и 100 ед./мл (колонии ровные, распространены по всей поверхности питательной среды ). При концентрации антибиотика 1000 ед./мл, растворённой в 4 мл питательного агара, микроорганизмы развиваются отдельными скоплениями, колонии неровные, мелкие, распространены по питательной среде неравномерно.
2. Во всех пробирках с различной концентрацией бензилбенициллина в питательной среде наблюдали развитие колоний культуры Bacillus cereus. Интенсивность роста колоний увеличивается с уменьшением концентрации антибиотика. Наименьшее развитие и распространение микроорганизмов наблюдали в пробирке с концентрацией 10000 ед./мл, наибольшее тАУ при концентрации 10 ед./мл, растворённой в 4 мл среды.
Выводы
1. Изучив чувствительность бактерий рода Bacillus к различным антибиотикам (пенициллин, ампициллин, стрептомицин), установили, что данные микроорганизмы наиболее чувствительны к ампициллину и стрептомицину, чувствительность к бензилпенициллину минимальна. Такую устойчивость к пенициллину можно объяснить возможностью некоторых представителей рода Bacillus (например, Bacillus subtilis и Bacillus cereus) образовывать фермент пенициллиназу, разрушающий пенициллин.
Что касается индивидуальной чувствительности, то наименее устойчивым к данным антибиотикам оказалась культура Bacillus subtilis. Bacillus mesentericus проявляет наибольшую устойчивость к стрептомицину и ампициллину, по сравнению с другими видами. К пенициллину самым устойчивым является Bacillus cereus.
2. В результате изучения влияния различных концентраций антибиотика, добавленного в питательную среду, на культуру Bacillus cereus, установили, что данный штамм устойчив даже к значительной концентрации бензилпенициллина (10000 ед./мл). Полученный результат доказывает возможность появления резистентности бактерий рода Bacillus к пенициллину, которая связана с образованием пенициллиназы.
Более чувствительным Bacillus cereus является по отношению к стрептомицину. Антибиотик концентрацией 10000 ед./мл, растворённый в 4 мл питательной среды полностью подавляет рост культуры, при концентрации 1000 ед./мл происходит угнетение роста, развитие минимальное.
Таким образом, стрептомицин оказывает большее влияние на бактерии рода Bacillus, чем пенициллин. Это объясняется широким спектром действия стрептомицина и тем, что многие чувствительные к пенициллину микроорганизмы относительно легко и быстро приобретают устойчивость к антибиотику.
Список литературы
1. Бриан Л. Бактериальная резистентность и чувствительность к химиопрепаратам / Перевод с англ. А. Я. Ивлевой. тАУ Москва: Медицина, 1984.- 270 с.
2. Воробьев А. А., Кривошеин Ю. С., Быков А. С. Основы микробиологии, вирусологии и иммунологии. Москва: Мастерство, 2001.- 224 с.
3. Гусев М. В., Минеева Л. А. Микробиология (третье издание). Москва: Издательство Московского университета, 1992.- с.
4. Егоров Н.С. Основы учения об антибиотиках (5-ое издание, переработанное и дополненное). Москва: Издательство Московского университета, 1994.- 512 с.
5. Ермольева З. В. Стрептомицин. Москва, Медгиз, 1956.- 59 с.
6. Гаузе Г. Ф. Лекции по антибиотикам (издание 2-ое, переработанное и дополненное). Москва, 1953.- 251 с.
7. Кашкин П. Н., Елинов Н. П. Антибиотики. Ленинград: Медицина, Ленинградское отделение, 1970.- 375 с.
8. Покровский В. Н. Антибиотики и бактерии. Москва: Знание, 1990. 64 с.
9. Сазыкин Ю. О. Биохимические основы действия антибиотиков на микробную клетку. Москва: Наука, 1965.- 267 с.
10. Шемякин Хохлов 1961
11. Дзержинская И. С. Методы выделения, исследования и определения антибиотической активности микроорганизмов, обладающих антагонистическими свойствами: Методические указания к практическим работам по дисциплине Антибиотики для студентов специальности 012400 ВлМикробиологияВ» / АГТУ.тАУ Астрахань, 2005.- 76 с.
Приложение 1
Рисунок 1. Чувствительность микроорганизмов (Bacillus subtilis, Bacillus mesentericus, Bacillus cereus тАУ на рисунке слева направо) к бензилпенициллину.

Приложение 2
Рисунок 2. Чувствительность микроорганизмов (Bacillus subtilis, Bacillus mesentericus, Bacillus cereus тАУ на рисунке слева направо) к ампициллину.
Вместе с этим смотрят:
Анатомическое строение растений
Анатомия и физиология заднего мозга. Строение и механизм кровообращения
Анатомо-физологические механизмы безопасности и защиты человека от негативного воздействия
Бiологiчне рiзноманiття людських рас